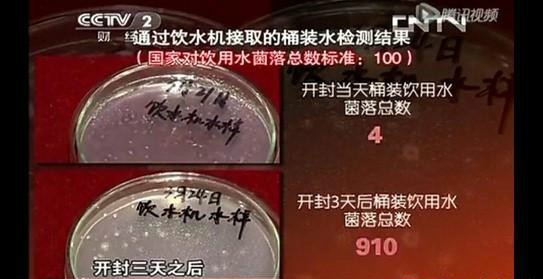

央視為何大力推崇凈水器?HSD-600G-1706實力證明!


近些年,央視不少頻道都有關(guān)于凈水器的報道,在不少欄目中,通過科普、實驗充分展現(xiàn)了凈水器功能的強大,甚至在綜藝節(jié)目中,也會出現(xiàn)很多凈水器的答題。能在全民性頻道中屢屢刷存在感,預示著凈水器已成為健康飲水生活新時代“代言人”。當然,凈水器之所以備受推崇,更重要的是以下原因——

一、自來水的一、二次污染
自來水的一次污染一般與當?shù)氐脑廴鞠嚓P(guān),即經(jīng)過自來水廠過濾后,依然達不到國家規(guī)定的飲用水標準。而二次污染則多來源于輸送管道,特別是年久失修的管道,污垢泛濫,銹跡斑斑,甚至導致自來水變色、變味。

二、水燒開就安全嗎?并不是!
在一些原水水質(zhì)較差的地區(qū),自來水中含有大量微生物、重金屬乃至致癌物。開水燒開后雖然可以殺滅部分微生物,但有害物質(zhì)難以消滅殆盡。同時,開水燒開后,細菌雖被殺死,但尸體仍然殘留在水體里,成為人體發(fā)熱的根源,即醫(yī)學上所說的“致熱質(zhì)”。

三、自來水加氯副作用明顯
目前自來水的凈化工藝,還基本上是傳統(tǒng)砂濾、絮凝、沉淀、加氯消毒的過濾凈化方式,整體是粗過濾方式,而加氯消毒工藝中氯與水中的腐黑素合成為三氯甲烷,是世界上公認的致癌物質(zhì)。當自來水燒至90至100度之間三氯甲烷是生水的3至4倍!

四、桶裝水也難保純凈之名
桶裝水未開封時,水質(zhì)自然安全有保障,但問題在于桶裝水開封后,細菌滋生數(shù)量會隨著飲用時間的增長而大幅度增加。在一則央視報道中對桶裝水菌落數(shù)作了測試,結(jié)果發(fā)現(xiàn)當日開封后桶裝水的菌落數(shù),而開封三天后菌落數(shù)驟增至910!

解決以上四大難題,安裝一臺合格的凈水器再合適不過。我們以漢斯頓熱銷品牌HSD-600G-1706為例——
★600GRO膜,過濾精度達0.0001微米,水中各類微生物、重金屬、細菌、病毒無處可逃。強大的過濾功能,讓自來水的一、二次污染不再可怕,無需燒開即可直飲。
★活性炭濾芯,有效過濾自來水中的余氯,讓水質(zhì)鮮活,不變色,無異味。同時添加口感因子,還原純凈水的真正味道,凈享甘甜、清冽。
★還在兩三天換一桶桶裝水?親,你OUT了!HSD-600G-1706,600G超大流量,接一杯250毫升凈水僅需10秒,1706RO膜,12倍制水速度,每小時制水量達90升,滿足全家用水需求。安全、穩(wěn)定、長久,用過才知道“真香”。




















